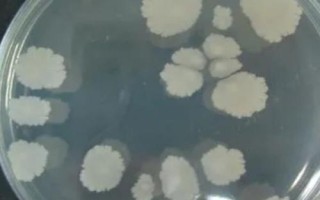
枯草芽孢杆菌的防治对象，可防治青枯病、溃疡病、性软腐等

敌敌畏兑水比例,用药前需仔细阅读使用说明
使用前,仔细阅读说明书,严格按说明用药。用药时,需穿好工作服、戴口罩等,避免药液与皮肤产生接触。用药过程中,禁止抽烟、饮食,药液浓度需保持在适宜范围内。碱性农药禁止和敌敌畏混用。随配随用,剩余药液需避...
07-19
枯草芽孢杆菌可以防治溃疡病、青枯病、细菌性软腐并等病害,适用于蔬菜、花卉、果树等作物,生产无公害及绿色产品时,也可以使用该药物。
枯草芽孢杆菌可以在植物的根际、体表、体内生存,它们与病原菌属于竞争关系,还会分泌抑制病原菌生长的物质,并诱导植物的免疫系统抵御病原菌,从而达到防治效果。

1、枯草芽孢杆菌防治对象:青枯病、溃疡病、细菌性软腐、细菌性穿孔等性病害。
2、枯草芽孢杆菌广泛适用于果树、蔬菜、园林花卉、中药材及大田作物。尤其适合无公害、绿色产品的生产。
1、枯草芽孢杆菌具有广谱活性和极强的抗逆能力。枯草芽孢杆菌不仅可以在土壤、植物根际体表等外界环境中广泛存在,而且是植物体内常见内生,尤其是在植物的根、茎部。目前该菌已经在水稻、大豆、棉花、小麦、辣椒、番茄、玉米等农作物上显示出很好的病害防治效果。
2、枯草芽孢杆菌通过成功定殖至植物根际、体表或体内,与病原菌竞争植物周围的营养,分泌物质以抑制病原菌生长,同时诱导植物防御系统抵御病原菌入侵,从而达到生防的目的。其主要防治对象为丝状所引起的植物病害,如水稻纹枯病、小麦纹枯病、番茄叶霉病、豆类根腐病、苹果霉心病、棉花立枯病、棉花枯萎病等。

1、枯草芽孢杆菌在大棚作物或者蔬菜苗期每袋兑水60公斤,叶面均匀喷洒或灌根,生长期和中后期每袋兑水30公斤叶面均匀喷洒或者灌根。
2、建议在早上10点前或下午4点后施药,防止阳光直射,杀死芽孢,尤其是在下午4点后用药,夜间潮湿的环境有助于芽孢萌发。

3、注意:不可与杀菌剂、抗生素、强酸、强碱类药物同时使用。
标签: 枯草芽孢杆菌的防治对象
相关文章
使用前,仔细阅读说明书,严格按说明用药。用药时,需穿好工作服、戴口罩等,避免药液与皮肤产生接触。用药过程中,禁止抽烟、饮食,药液浓度需保持在适宜范围内。碱性农药禁止和敌敌畏混用。随配随用,剩余药液需避...
07-19
马拉硫磷可用于水稻、麦类、棉花、蔬果等作物,主要用于防治粘虫、蚜虫、叶蜂、食心虫、叶甲、尺蛾、毒蛾、盲蝽蟓、菜青虫、介壳虫等多种害虫。马拉硫磷对人畜毒性低、对农作物药害小,但是稳定性较差,容易分解,因...
08-13
常见农药剂型及其简写符号如下:原药(TC)、干拌种剂(DS)、悬浮种衣剂(FS)、种衣剂(SD)、湿拌种剂(WS)、水剂(AS)、乳油(EC)、悬浮剂(SC)、悬乳剂(SE)、颗粒剂(GR)、可湿性粉...
02-11
芹菜不宜施加尿素,因为追施大量氮肥后,容易导致芹菜纤维增多、变粗、商品价值下降。禾谷类作物:叶面喷施1.5-2%尿素溶液。茄果类:叶面喷施0.3%尿素溶液。果树:叶面喷施0.5%尿素溶液。一、哪种蔬菜...
08-29
草甘膦的毒性较小,属于低毒除草剂,对动物刺激性有限,不会在动物体内积累,也未显示致畸、致突变或致癌作用。草甘膦为内吸除草剂,施药时应避免漂移,稀释农药时需用清洁软水稀释,使用草甘膦后3天内不可割草、放...
05-13
细菌病害:用50-65克辛菌胺醋酸盐水剂+水15千克,混合制成喷雾,均匀喷施在叶片的正反面。真菌病害:发病初期用50克辛菌胺醋酸盐水剂+水15千克均匀喷施,每隔一周使用一次。病毒病害在:发病初期用50...
08-23
防虫类型:喹硫磷可以灭杀蚜虫、烟青虫等蔬菜害虫,矢尖蚧、黑点蚧等果林害虫,盲象、蓟马、红蜘蛛等棉花害虫,稻纵卷叶螟、二化螟等水稻害虫。用药方式:防治蔬菜蚜虫,亩用25%喹硫磷乳油40毫升兑水喷雾。防治...
09-11
尿液做肥料具有耗费时间长、有一定危险性、可用其它化肥代替、难以把握发酵尺度等缺点。耗费时间长:施用尿液之前要进行发酵处理,这比直接购买化肥更耗费时间。有一定危险性:尿液发酵期间会产生异味和甲烷气体,处...
08-17
测土施肥:了解土壤的性质和养分含量,再采取改良措施。基肥:播种时,将复合肥作为底肥施入,若在苗期、种植中后期使用,容易导致作物徒长。浓度:低浓度复合肥,养分含量为25-30%左右。中浓度复合肥,养分含...
08-01
土壤质地太粘:粘土壤中的粘粒含量较多,土壤通气透水、增温性较差,下雨或灌水以后易堵塞,所以极易造成壤板结。有机质含量不足:有机质没有及时补充,含量低,导致结构变差,影响微生物活性,导致土壤板结。长期单...
06-13
热点文章
富尔5152玉米栽培技术要点,种植密度每亩5500株
不锈钢锅能不能长期放醋,不可长期盛放
凤尾竹冬季如何浇水,凤尾竹不耐严寒怕冻
扬麦21小麦栽培技术要点,该品种表现幼苗直立
L2318玉米栽培技术要点,适宜播种期4月下旬至5月上旬
工厂化生产番茄每平方米面积的产量,一般可以超过30公斤
吉育654大豆栽培技术要点,高抗大豆灰斑病
碗莲入泥定植的方法,将种子播入花土中再浇水淹没